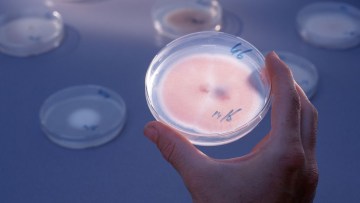
Eredeti formuláció, valódi teljesítmény

A Szakmai Ártalom legújabb adásában az olajos növények piacát próbáljuk közérthetően körbejárni Potori Norbert agrárpiaci elemző segítségével. Mi mozgatja valójában a napraforgó és a repce felvásárlási árait? Mennyire számítanak a hazai vetésterületek, és mennyire írja felül a magyar piacot a világpiac? Beszélünk többek között:
• a MATIF és a nemzetközi árutőzsdék szerepéről, • arról, hogy termelőként milyen piaci jelzéseket érdemes figyelni, • Ukrajna és Kanada hatásáról az olajos piacokra, • a kőolaj és a növényi olajok kapcsolatáról, • az EU importhelyzetéről, • a geopolitikai konfliktusok árupiaci következményeiről, • az El Niño hatásáról, • valamint a megújulóenergia-direktívák olajos növényekre gyakorolt hatásáról is.
Kitérünk arra is, hogy a hazai napraforgó-terület növekedése milyen hatással lehet a kereslet-kínálati viszonyokra, és hogy hosszabb távon milyen kilátások előtt állhatnak az olajos kultúrák. Az adás célja nem a napi árak megjóslása, hanem az, hogy segítsünk eligazodni egy folyamatosan változó piaci környezetben.
north_east Tovább az adásra